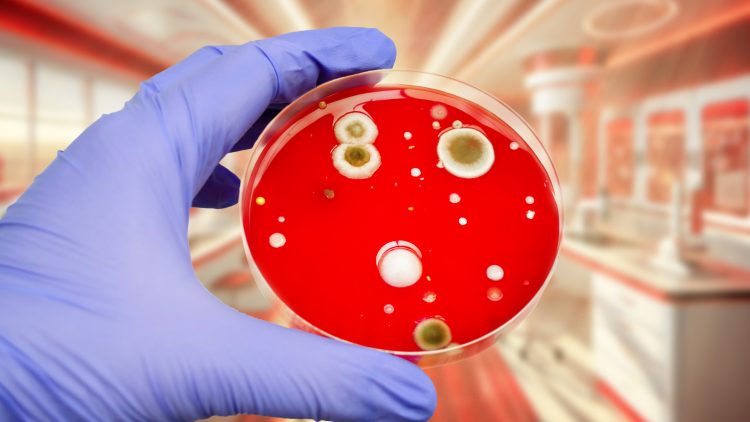
Академик назвал меры для борьбы с устойчивостью бактерий к лекарствам

Депутаты обсуждают доплату медикам и фармацевтам
Ежегодную выплату для медиков, фармацевтов, научных работников, учителей, работников культуры предлагают установить депутаты Сергей Миронов и Александр Бабаков. Выплата будет назначаться территориальным органом Фонда пенсионного и социального страхования РФ, сообщает ТАСС.
Подобную инициативу Сергей Миронов, лидер фракции «Справедливая Россия — За правду», и Александр Бабаков, зампред ГД, представили на рассмотрение парламента. В законопроекте депутаты предлагают установить ежегодную выплату для наиболее социально важных категорий работников — педагогов, медработников, фармацевтов, работников культуры и научных работников. «Она должна равняться 7% от уплаченного НДФЛ за год. Если Госдума законопроект примет, то работники социальной сферы смогут ежегодно получать дополнительную выплату», – так пояснил суть инициативы Сергей Миронов.
В соответствии с проектом закона выплаты будут осуществляться территориальным отделением Фонда пенсионного и социального страхования Российской Федерации за счет средств федерального бюджета, выделенных в рамках межбюджетных трансфертов. Порядок выплат установит правительство.
Парламентарий подчеркнул, что речь идёт о создании в регионах дополнительного инструмента для привлечения молодых кадров в отрасли, где наиболее остро ощущается нехватка специалистов.
В марте 2025 года Сергей Миронов предложил на рассмотрение законопроект о субсидиях на лекарства для малоимущих, если расходы на лекарства превышают 10% дохода семьи. Однако ГД его отклонила, поскольку проект не имел заключения правительства.
Фото: vertolet © 123RF.com